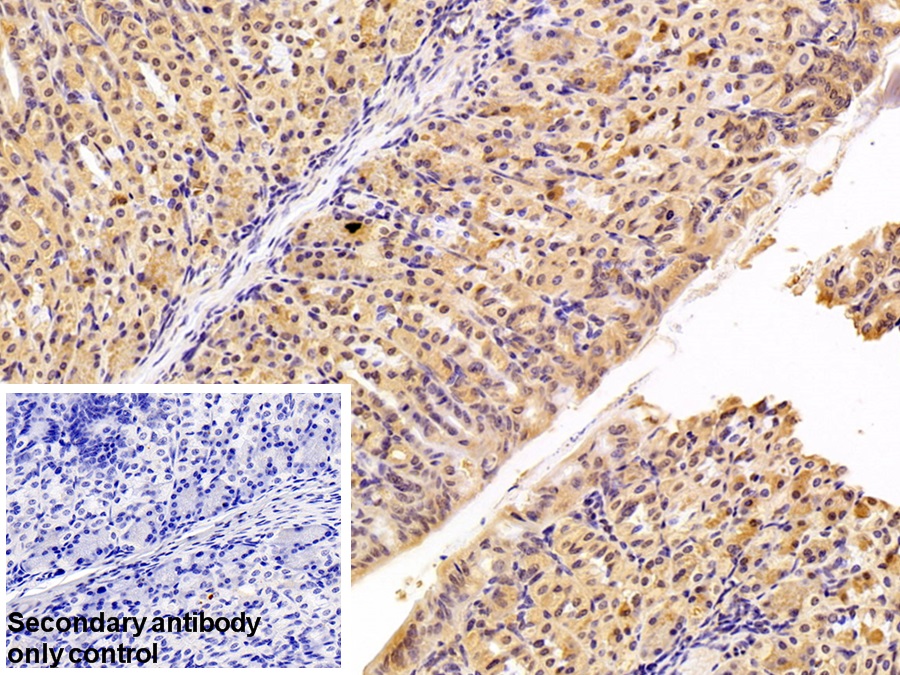

亲环素A(CYPA)多克隆抗体
Polyclonal Antibody to Cyclophilin A (CYPA)
PPIA; CyP-A; CYPH; Peptidylprolyl Isomerase A; Peptidyl-Prolyl Isomerase A; Peptidyl-prolyl cis-trans isomerase A; Cyclosporin A-binding protein
- 编号PAA979Mu01
- 物种Mus musculus (Mouse,小鼠)相同的名称,不同的物种。
- 来源多抗制备
- 宿主兔
- 效价-
- Ig类型IgG
- 纯化方式抗原特异性亲和纯化
- 标记物无标记物
- 免疫原RPA979Mu01-亲环素A(CYPA)重组蛋白
- 缓冲液成份0.01M 磷酸盐缓冲液(pH7.4,containing 0.05% Proclin-300,50% glycerol)
- 性状液体
- 浓度0.5mg/mL
- 且适物种Homo sapiens (Human,人)
- 应用WB,IHC,ICC/IF
如果抗体需用于流式细胞术,请参见流式抗体。 - 下载英文说明书 中文说明书
- 规格20µl100µl200µl1ml10ml
- 价格¥ 583¥ 1361¥ 1944¥ 4860¥ 19440
- 欲了解实际交易价格和更多情况,请与当地经销商联系!
特异性
该抗体是针对CYPA的兔多克隆抗体。在免疫组织化学染色和免疫印迹实验中能识别CYPA。
用法
Western blotting: 0.01-2µg/mL;
Immunohistochemistry: 5-20µg/mL;
Immunocytochemistry: 5-20µg/mL;
Optimal working dilutions must be determined by end user.
储存
经常使用则4°C保存。-20°C保存不超过两年。避免反复冻融。
稳定性
热稳定性以损失率显示。损失率是由加速降解试验决定,具体方法如下:在37°C孵育48小时,没有显著的降解或者沉淀产生。保质期内,在适当的条件下存储,损失率低于5%。
赠品
增值服务
相关产品
| 编号 | 适用物种:Mus musculus (Mouse,小鼠) | 应用(仅供研究使用,不用于临床诊断!) |
| RPA979Mu01 | 亲环素A(CYPA)重组蛋白 | Positive Control; Immunogen; SDS-PAGE; WB. |
| RPA979Mu02 | 亲环素A(CYPA)重组蛋白 | Positive Control; Immunogen; SDS-PAGE; WB. |
| PAA979Mu02 | 亲环素A(CYPA)多克隆抗体 | WB |
| PAA979Mu01 | 亲环素A(CYPA)多克隆抗体 | WB,IHC,ICC/IF |
| FAA979Mu01 | 抗亲环素A(CYPA)多克隆抗体 | FCM |
| LAA979Mu81 | 亲环素A(CYPA)多克隆抗体(异硫氰酸荧光素标记) | WB; IHC; ICC; IF. |
| LAA979Mu71 | 亲环素A(CYPA)多克隆抗体(生物素标记) | WB; IHC; ICC. |
| MAA979Mu24 | 亲环素A(CYPA)单克隆抗体 | FCM |
| MAA979Mu27 | 亲环素A(CYPA)单克隆抗体 | ICC/IF,FCM |
| MAA979Mu25 | 亲环素A(CYPA)单克隆抗体 | WB,IHC |
| MAA979Mu26 | 亲环素A(CYPA)单克隆抗体 | WB,ICC/IF |
| MAA979Mu21 | 亲环素A(CYPA)单克隆抗体 | WB; IHC |
| MAA979Mu22 | 亲环素A(CYPA)单克隆抗体 | WB; IHC |
| HEA979Mu | 亲环素A(CYPA)检测试剂盒(酶联免疫吸附试验法,高敏型) | Enzyme-linked immunosorbent assay for Antigen Detection. |
| SEA979Mu | 亲环素A(CYPA)检测试剂盒(酶联免疫吸附试验法) | Enzyme-linked immunosorbent assay for Antigen Detection. |
| LMA979Mu | 亲环素A(CYPA)等多因子检测试剂盒(流式荧光发光法) | FLIA Kit for Antigen Detection. |
| PSA979Mu01 | 亲环素A(CYPA)抗体对 | ELISA; CLIA; ELISPOT; Luminex; Immunochromatography and other Immunoassays. |
| KSA979Mu01 | 亲环素A(CYPA)检测试剂盒DIY材料(酶联免疫吸附试验法) | Main materials for "Do It (ELISA Kit) Yourself". |
参考文献
| 杂志 | 参考文献 |
| Atherosclerosis | EMMPRIN and its ligand cyclophilin A regulate MT1-MMP, MMP-9 and M-CSF during foam cell formation[PubMed: 19758589] |
| Biomarkers | Cyclophilin-A: a novel biomarker for untreated male essential hypertension[Pubmed: 24164594] |
| Cardiovascular Diabetology | Plasma level of cyclophilin A is increased in patients with type 2 diabetes mellitus and suggests presence of vascular disease[Pubmed:24502618] |
| International Journal of Biological Sciences | Decrease in Plasma Cyclophilin A Concentration at 1 Month after Myocardial Infarction Predicts Better Left Ventricular Performance and Synchronicity at 6 Months: A Pilot Study in Patients with ST Elevation Myocardial Infarction[Pubmed:25552928] |
| Medicine | Cyclophilin A in Ruptured Intracranial Aneurysm[PubMed: 26426668] |
| Mol Cell Biochem | PPIA rs6850: A> G single-nucleotide polymorphism is associated with raised plasma cyclophilin A levels in patients with coronary artery disease[PubMed: 26702934] |
| Medicine (Baltimore) | Urinary Cyclophilin A as a New Marker for Diabetic Nephropathy: A Cross-Sectional Analysis of Diabetes Mellitus[PubMed: 26496315] |
| International Journal of Cardiology | Cyclophilin A modulates bone marrow-derived CD117(+) cells and enhances ischemia-induced angiogenesisvia the SDF-1/CXCR4 axis.[Pubmed:27057951] |
| Clinica Chimica Acta | Novel findings of secreted cyclophilin A in diabetic nephropathy and its association with renal protection of dipeptidyl peptidase 4 inhibitor[pubmed:27823952] |
| Cardiovascular Diabetology | Cyclophilin A enhances macrophage differentiation and lipid uptake in high glucose conditions: a cellular mechanism for accelerated macro vascular disease in diabetes mellitus.[pubmed:27809851] |
| Clinical Science | Metformin attenuates effects of cyclophilin A on macrophages, reduces lipid uptake and secretion of cytokines by repressing decreased AMPK activity[Pubmed:29382697] |
| Journal of Molecular Histology | Cyclophilin a increases CD68 cell infiltration in rat experimental periodontitis[Pubmed:29318411] |
| Free Radical Research | Cyclophilin A and CD147 associate with progression of diabetic nephropathy[Pubmed: 30572748] |
| The Kaohsiung Journal of Medical Sciences | Association of cyclophilin A level and pulse pressure in predicting recurrence of cerebral infarction[Pubmed: 31670477] |
| Cells. | Cyclophilin A/EMMPRIN Axis Is Involved in Pro-Fibrotic Processes Associated with Thoracic Aortic Aneurysm of Marfan Syndrome Patients[Pubmed: 31936351] |
| JAMA Neurology | APPENDIX A: Relationship between cyclophilin A levels and matrix metalloproteinase-9 activity in cerebrospinal fluid of cognitively normal apolipoprotein E4 carriers …[Pubmed: 24030206] |
| Menoufia Medical Journal | Urinary podocalyxin and cyclophilin A: markers for early detection of type 2 diabetic nephropathy[] |
| Toxins | Evaluation of the Therapeutic Effects of Protocatechuic Aldehyde in Diabetic Nephropathy[34437430] |
| Cell Death & Disease | Proteomic analysis reveals USP7 as a novel regulator of palmitic acid-induced hepatocellular carcinoma cell death[Pubmed:35732625] |